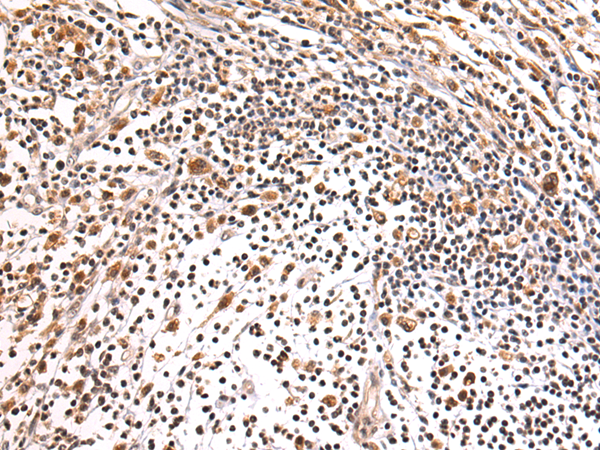

-
分类: 科研抗体货号: P10380别名: PKC; EKD1; ICCA; BFIC2; BFIS2; DSPB3; DYT10; FICCA; IFITMD1应用: IHC反应种属: Human, Mouse, Rat
-
分类: 科研抗体货号: P10381别名: RFC36应用: WB反应种属: Human, Mouse
-
分类: 科研抗体货号: P10379别名: AP-4; bHLHc41应用: IHC反应种属: Human
-
分类: 科研抗体货号: P10395别名: BAP28; UTP10应用: WB,IHC反应种属: Human
-
分类: 科研抗体货号: P10378别名: MSI2H应用: IHC反应种属: Human
-
分类: 科研抗体货号: P10394别名: EMI; gp115; EMILIN应用: WB,IHC反应种属: Human, Mouse
-
分类: 科研抗体货号: P10376别名: FX; P35B; SDR4E1应用: IHC反应种属: Human, Mouse
-
分类: 科研抗体货号: P10393别名: C16orf48; DAKV6410应用: WB,IHC反应种属: Human, Mouse
-
分类: 科研抗体货号: P10403别名: CEP123; CCDC123应用: IHC反应种属: Human
-
分类: 科研抗体货号: P10392别名: KE04; KEO4; SPFH1; SPG62; Erlin-1; C10orf69应用: WB,IHC反应种属: Human, Mouse, Rat

鄂公网安备42018502007531号
鄂公网安备42018502007531号

